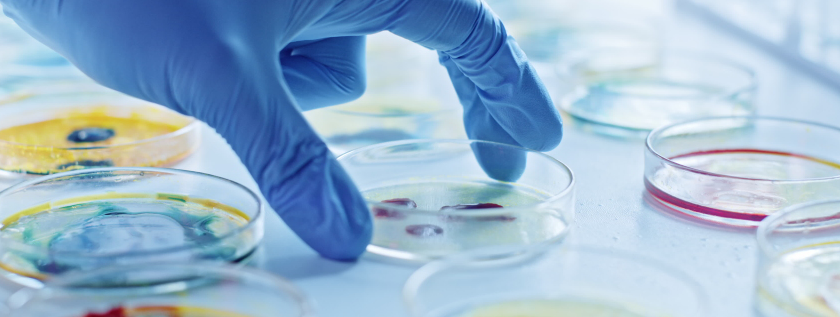

Call us
+91 9494158641
E-mail us
kiran65@ssrbiosciences.com
Phytochemistry And Pharmaceutical Biotechnology
Phytochemistry is associated with the isolation and identification of active chemical constituents of plants, which aids in the development of novel therapeutic drugs. Phytochemicals have tremendous medical significance because of their therapeutic impacts on human health, such as antioxidant, antimicrobial, anticancer, and antidiabetic properties, etc. Pharmaceutical biotechnology is a new and emerging field that focuses on the discovery of novel vaccines, medications, and therapies based on biotechnology principles. Bioformulations developed through pharmaceutical biotechnology, such as antibodies, nucleic acid derivatives, and vaccines, etc., account for the majority of the current pharmaceutical business. Therefore, pharmaceutical biotechnology offers a platform for innovative research and unique discoveries to address several diseases which lack proper medicines.
Services
- Solvent extraction of phytochemicals
- Screening of phytochemicals
- Separation of bioactive phytocompounds
- Identification and characterisation of bioactive compounds
- Antioxidant studies
- Antimicrobial studies
- Antidiabetic studies
- Anticancer studies
- Antiinflammatory studies
